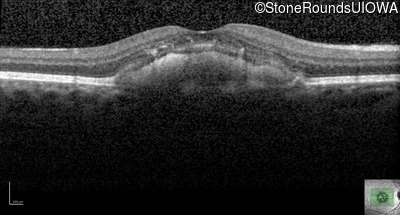
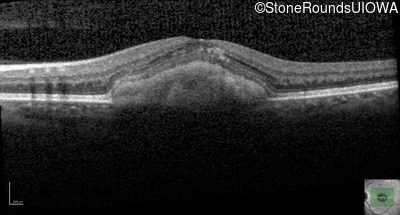
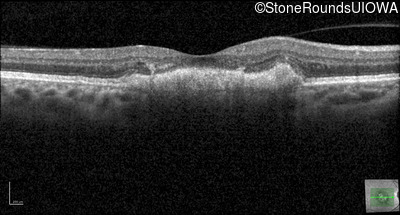
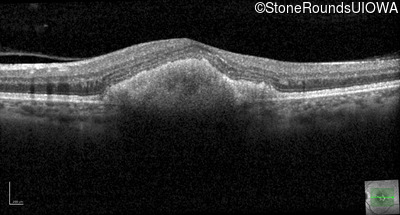

Case
SR3008
Student Mode
Pattern Dystrophy (IIC)
Female
Female
Hidden
SR3008
Student Mode
Pattern Dystrophy (IIC)
Female
Female
Highlighted Images
| Age at visit: 29 years | OD | OS |
|---|---|
History
This 29 year old woman recently had macular abnormalities noticed on routine eye exam. She has noticed some reduction of her central vision after exposure to bright light which slowly recovers over a period of minutes.
| Age at visit: 29 years |
| OD | OS | ||
|---|---|---|---|
| OD | OS | ||
|---|---|---|---|
| OD | OS | ||
|---|---|---|---|
| Age at visit: 36 years |
| OD | OS | ||
|---|---|---|---|
| Age at visit: 39 years |
| OD | OS | ||
|---|---|---|---|
| Age at visit: 53 years |
Diagnosis & molecular findings
| Disease | Gene | Allele 1 variant(s) | Allele 2 variant(s) | Inheritance mode |
|---|---|---|---|---|
| Pattern Dystrophy | PRPH2 | Gly167Asp GGC>GAC | AD |